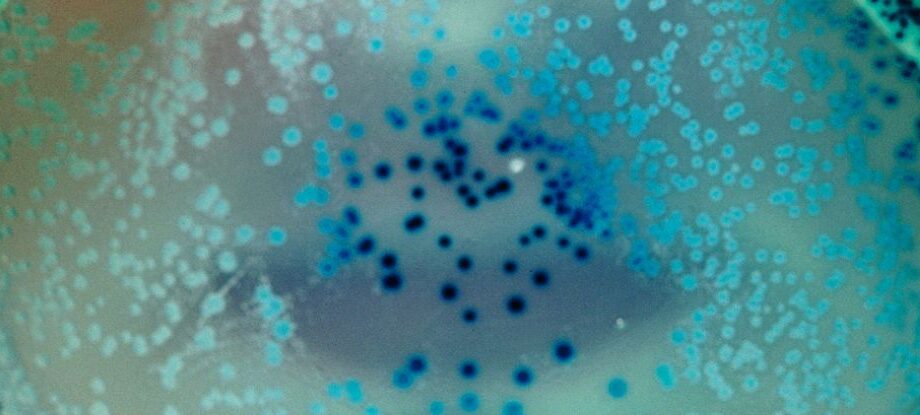

This website uses the following additional cookies:
ID Company name
2 Captify Technologies Limited
11 Quantcast International Limited
12 BeeswaxIO Corporation
16 RTB House S.A.
21 The Trade Desk
23 Amobee Inc.
25 Yahoo EMEA Limited
39 ADITION technologies GmbH
40 Active Agent (ADITION technologies GmbH)
50 Adform
68 Sizmek by Amazon
71 Roku Advertising Services
73 Simplifi Holdings Inc
76 PubMatic, Inc.
79 MediaMath, Inc.
87 Betgenius Ltd
91 Criteo SA
128 BIDSWITCH GmbH
129 IPONWEB GmbH
142 Media.net Advertising FZ-LLC
151 Admedo Technology Ltd
156 Centro, Inc.
161 Smadex SL
238 StackAdapt
253 Improve Digital
254 LiquidM Technology GmbH
264 Adobe Advertising Cloud
284 Weborama
316 Gamned
382 The Reach Group GmbH
423 travel audience GmbH
469 Zeta Global
565 Adobe Audience Manager, Adobe Experience Platform
655 Sportradar AG
755 Google Advertising Products
776 Mars Media Group
793 Amazon Advertising
922 Amnet GmbH
990 QuantumCast digital GmbH
32 Xandr
45 Equativ
52 Magnite, Inc.
102 Magnite, Inc. (Outstream)
81 PulsePoint
10 Index Exchange, Inc.
114 Sublime
164 Outbrain UK Ltd
42 Taboola Europe Limited
13 Sovrn Holdings Inc
183 EMX Digital LLC
165 SpotX, Inc
259 ADYOULIKE SA
132 Teads
72 Nano Interactive GmbH
724 Between Exchange
62 Justpremium BV
69 OpenX
639 Smile Wanted Group
241 OneTag Limited
108 Rich Audience Technologies SL
28 TripleLift, Inc.
617 Onfocus (Adagio)
511 Admixer EU GmbH
816 NoBid, Inc.
138 ConnectAd Realtime GmbH
606 Impactify
436 INVIBES GROUP
80 Sharethrough, Inc
924 Viewdeos 2015 LTD
799 Adpone SL
90 Teroa S.A.
410 Adtelligent Inc.
780 Aniview LTD
666 BeOp
24 Epsilon
781 FeedAd GmbH
737 Monet Engine Inc
210 Zemanta, Inc.
610 Azerion Holding B.V.
31 Ogury Ltd.
157 Seedtag Advertising S.L
61 GumGum, Inc.
434 DynAdmic
484 SublimeSkinz - Adledge
301 ZEOTAP
380 Vidoomy Media SL
244 Ermes
687 Missena
95 Lotame Solutions, Inc
1028 Sparteo
1135 Opera Software Ireland Limited
231 AcuityAds Inc.
1265 The Moneytizer
1132 Luponmedia
358 MGID Group
1134 Bidmatic Inc.
842 PubWyse, LLLP
36 Nexxen Group LLC
142 Media.net Advertising FZ-LLC
111 Showheroes SE
276 ShowHeroes SRL
1111 152 Media LLC
58 33Across
131 ID5 Technology Ltd
97 LiveRamp
148 LiveIntent Inc.
779 Adtarget Teknoloji A.S.
1148 ORANGE CLICK MEDIA & COMMERCE LTD
918 SPORTORITY UK LTD
561 AuDigent
1165 Kueez Entertainment Ltd.
285 Comcast International France SAS/FreeWheel Media, Inc.
1043 TypeA Holdings Ltd
1083 Seven Technologies S.L.
1288 TStack Inc